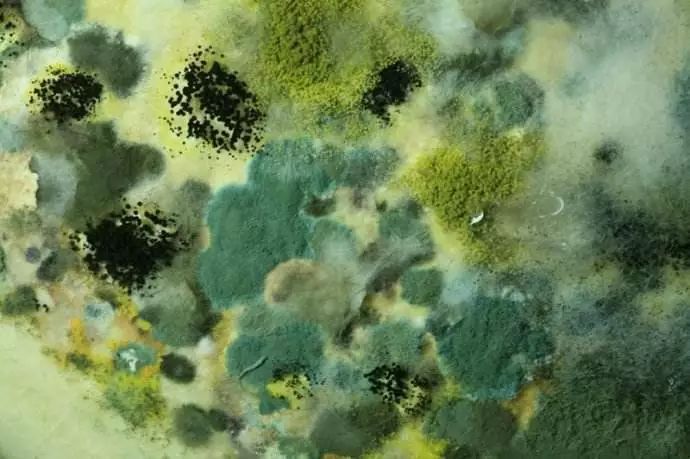
【健康】臭豆腐的配料里竟有屎?还能不能吃了

大便发黑,或与这5个因素有关,希望你不会轻易
640x480 - 41KB - JPEG

大便黑色不成形是怎么回事
480x300 - 45KB - JPEG

吃茵栀黄口服液宝宝大便这个颜色吗?
600x800 - 86KB - JPEG

医生:晨起1种大便前硬后软,这种迹象早在引
539x317 - 27KB - JPEG
【健康】臭豆腐的配料里竟有屎?还能不能吃了
690x459 - 53KB - JPEG

跟风茶虫,你喝的到底是药还是带毒的屎?
580x395 - 31KB - JPEG
早上的大便别忽视,预示身体出现异样,可能是癌
360x384 - 15KB - JPEG

大便黑色是什么原因 警惕导致大便变黑的原因
400x400 - 29KB - JPEG
上完厕所别慌走,看一眼这个等于做了次免费体
194x359 - 23KB - JPEG
上完厕所别慌走,看一眼这个等于做了次免费体
194x368 - 19KB - JPEG
通过便便看健康:快来测测你健康么? - 今日头条
330x500 - 16KB - JPEG

邦友金蛋蛋分享的磷酸二氢钾到了。
480x640 - 58KB - JPEG
健康自测 | 七种壮观便便大排行,你是哪种? - 今
450x489 - 14KB - JPEG

【周末故事书】大便书--你有好好看过自己的便
240x320 - 16KB - JPEG
吃了30年才学会,蛋黄上插一根牙签太厉害了,学
600x400 - 21KB - JPEG
3、颜色是否对。动物蛋白太多,胆和肝脏压力过大,胆法分泌不够,长久的褐色大便会造成酸性体质,即是慢性
其实很多时候每天排出来的大便,通过大便的颜色来传达我们身体健康情况是怎么样的,那么大便颜色红褐色是
病情分析:你好,根据你的描述,考虑你的大便颜色呈红褐色是由于饮食的大便颜色经常为褐色,有时候是黄色
病情描述:我这两天吃了馅菜,然后它的颜色是比较红的,然后这两天大便都是一样的都是红褐色的不知道是怎么
如果大便的颜色是过于深褐色状,可以判断和癌症便血有关系。胆法分泌不够,长久的褐色大便会造成酸性
孩子现在大便颜色成红褐色,请问是药物的作用吗?还是吃的专门拉肚奶粉的效果,现在奶粉还能吃吗?谢谢
肚子受冷就会咕咕响,声音想拉肚子颜色也可从黑色进一步转化为红褐色甚至鲜红色。只有当上消化道的出血量
大家都知道大便的颜色和人体的身体如果发现大便出现了红褐色的现象,也不必过于着急,很多时候大便红褐色是